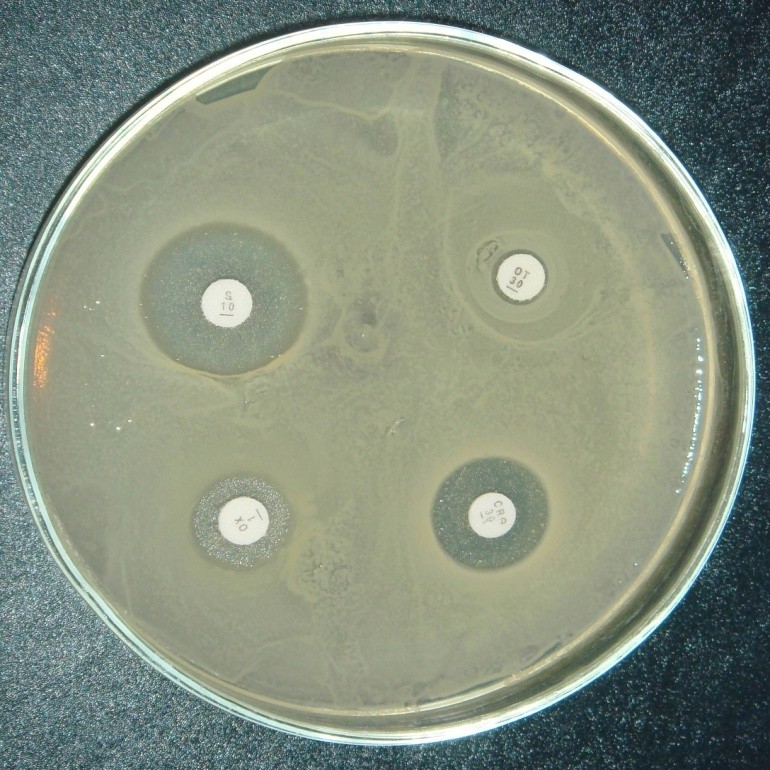

محیط کشت ژلاتین مدیوم کیولب
0
0
Gelatin Medium. Quelab
محیط کشت
.
محیط کشت افتراقی
.
محیط کشت براث
.
محیط کشت کیولب
.
محیط کشت میکروبی
.
مواد زیستی